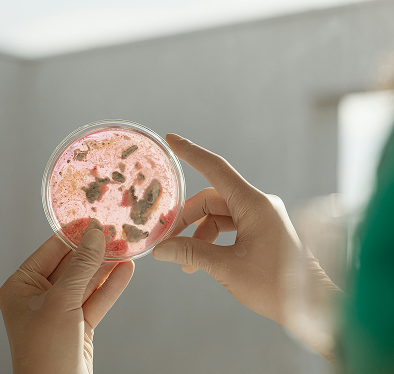
Gut Microbiome Analysis

You finally have time to enjoy your health — but only if you optimise it.
Our expert guidance and bleeding-edge treatments keep you doing what you love — whether that’s touring Italy, or catching every day’s first wave.
Enjoy What You’ve Earned
In retirement, you’ll have the most time — make sure you also have the most freedom.
A Trusted Navigator
Doctor Hunt’s 35 years of medical expertise will guide you through the latest medical advancements.
A Holistic, Considered Approach
Go beyond hurried, reactive GP treatments, with deep diagnostics and long-term partnership.

Guided by Doctor Hunt, as seen on












Living longer doesn’t necessarily mean living better.
Average lifespans have been increasing for decades — but for too many, that means expanding the time spent living without freedom or independence in their final decades of life. We’re working to turn that around — to give our patients a healthspan that closely matches their lifespan.
Your future deserves more than reactive medicine.
Under-resourced and overbooked, GPs have to work fast and focus on the obvious, immediate issues. At Longevity Clinics, we approach your longevity with the patience they can’t afford, and the bleeding-edge treatments they haven’t had time to familiarise themselves with.
The Old Way
Our Way
The old ways weren’t built to improve old age.
Our diagnostic tools
Our bleeding-edge treatments

A future-focused approach. Guided by a leading expert.
As you likely know from your own experiences, becoming and remaining an expert requires decades of experience and the drive to stay on the cutting edge — which is why we’re fortunate to be led by Doctor Jeremy Hunt.
35+ years of experience
10,000+ patients treated
Appointed Supervisor for Aesthetic Surgical Training by the Royal Australian College of Surgeons
Doctor Hunt’s philosophy
01
Explore bleeding-edge treatments...
...but stay grounded in medical research.
02
Don’t just extend life...
...improve quality of life.
03
Don’t just treat the symptom...
...untangle and address the cause.
04
Building longevity requires the patient to invest time in our plan...
...and requires us to invest time in the patient.
















Your guided path to a maximised healthspan.
We act as your navigator and concierge, cutting through both the misinformation and bureaucracy on your path to longevity.
Discovery Form
You start by sharing your health goals and history.
Discovery Call
A Registered Nurse organises your initial call to ensure we’re the right fit.
Specialist Consult
In-depth consultation with a specialist Longevity Doctor.
Tailored Diagnostics
We arrange your custom set of health tests and scans.
Custom Treatment Plan
We develop your plan, leveraging the latest medical treatments.
Ongoing Partnership
Regular check-ins to monitor progress and modify your plan for long-term results.
Real patients, real freedom.
Don't just take our word for it — hear from real patients who know that your future health deserves just as much investment as your superannuation.
"I had such a great experience here! From the moment I walked in, the staff were incredibly courteous, friendly, and genuinely caring."
Andrew Z
Booked for my second IV drip which will be immunity IV after the NAD anti ageing which was fantastic.
Cameron L
"Staffs knowledge and professionalism make me feel very comfortable."
Mark Jo
"I had such a great experience here! From the moment I walked in, the staff were incredibly courteous, friendly, and genuinely caring."
Andrew Z
Booked for my second IV drip which will be immunity IV after the NAD anti ageing which was fantastic.
Cameron L
"Staffs knowledge and professionalism make me feel very comfortable."
Mark Jo
"Just started my gut health journey with Longevity Clinic and already impressed! The team is knowledgeable, supportive and focused on long-term wellness, not just quick fixes."
Mk
"The manager clearly runs a tight ship; the whole place is clean, organized, and everyone works together like a well-oiled team. You can tell they really care about their patients."
Andrew Z
Booked for my second IV drip which will be immunity IV after the NAD anti ageing which was fantastic.
Cameron L
"Just started my gut health journey with Longevity Clinic and already impressed! The team is knowledgeable, supportive and focused on long-term wellness, not just quick fixes."
Mk
"The manager clearly runs a tight ship; the whole place is clean, organized, and everyone works together like a well-oiled team. You can tell they really care about their patients."
Andrew Z
Booked for my second IV drip which will be immunity IV after the NAD anti ageing which was fantastic.
Cameron L
"They took the time to explain everything and made me feel completely comfortable and at ease before and during my procedure — which means a lot when you’re a little nervous!"
Andrew Z
Booked for my second IV drip which will be immunity IV after the NAD anti ageing which was fantastic.
Cameron L
"Staffs knowledge and professionalism make me feel very comfortable."
Mark Jo
"They took the time to explain everything and made me feel completely comfortable and at ease before and during my procedure — which means a lot when you’re a little nervous!"
Andrew Z
Booked for my second IV drip which will be immunity IV after the NAD anti ageing which was fantastic.
Cameron L
"Staffs knowledge and professionalism make me feel very comfortable."
Mark Jo
Book your free discovery call now.
Questions before you invest?
We operate in the valuable middle ground between overburdened, reactive GPs and dangerous, unregulated "wellness" fads. Our expertise, guided by Doctor Hunt's 35 years of experience, ensures that every innovative treatment we offer is safe, evidence-based, and tailored to your precise biological needs.
No two patients are the same. The efficacy of any treatment depends wildly on the complex variable that is you—your biology, environment, habits, and goals. We invest the time to conduct wide-ranging diagnostics and in-depth consultations developing a custom treatment plan that works for your unique life path.
Your financial freedom is only as valuable as the time and experiences it affords, and those experiences are only as valuable as your ability to enjoy them to the fullest. Maximising your healthspan is an exercise in maximising your most significant investment, ensuring you reap the dividends of a lifetime of hard work—free from pain and full of vitality.
This is a zero-obligation, low-friction start to your journey. You'll speak with one of our Registered Nurses to outline your current health status and goals. This ensures we understand your needs and confirm that an in-depth specialist consultation with our doctors is the right, high-value next step for you.